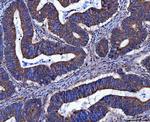
FRY Antibody in Immunohistochemistry (Paraffin) (IHC (P))

Search
Invitrogen
FRY Polyclonal Antibody
{{$productOrderCtrl.translations['antibody.pdp.commerceCard.promotion.promotions']}}
{{$productOrderCtrl.translations['antibody.pdp.commerceCard.promotion.viewpromo']}}
{{$productOrderCtrl.translations['antibody.pdp.commerceCard.promotion.promocode']}}: {{promo.promoCode}} {{promo.promoTitle}} {{promo.promoDescription}}. {{$productOrderCtrl.translations['antibody.pdp.commerceCard.promotion.learnmore']}}
图: 1 / 8
FRY Antibody (PA5-143851) in IHC (P)

Please note: We are reviewing Western blot images included in the antibody testing data in our catalog, including those provided by third parties. Unless expressly labeled or annotated as “raw-unedited”, Western blot images included in the antibody testing data in our catalog may have been edited, optimized or otherwise adjusted for presentation.
产品信息
PA5-143851
种属反应
宿主/亚型
分类
类型
抗原
偶联物
形式
浓度
规格
纯化类型
保存液
内含物
保存条件
运输条件
RRID
产品详细信息
Adding 0.2 mL of distilled water will yield a concentration of 500 µg/mL.
Positive Control - WB: human RT4 whole cell, human Caco-2 whole cell, rat brain tissue, rat lung tissue, mouse brain tissue, mouse lung tissue. IHC: human colorectal adenocarcinoma tissue, human liver cancer tissue, human lung cancer tissue, human ovarian cancer tissue, human penis squamous cell carcinoma tissue. Flow: SiHa cell.|Store at -20°C for one year from date of receipt. After reconstitution, at 4°C for one month. It can also be aliquotted and stored frozen at -20°C for six months. Avoid repeated freeze-thaw cycles.
靶标信息
The FRY gene encodes a protein known as furry homolog (FRY), a gene that is highly conserved across species and plays vital roles in cell division and differentiation. FRY is involved in the regulation of mitotic spindle orientation and cellular polarity, crucial for proper cell division and tissue organization. It is found within various tissues and has implications in neurodevelopment and cancer biology, where it influences cell structural properties and signaling pathways. Alterations in FRY expression or mutations can disrupt normal cell function, leading to aberrant cellular morphogenesis and developmental defects. In cancer studies, FRY is associated with tumor suppression, where loss of function contributes to uncontrolled cell proliferation. This gene interacts with other cellular components, such as the cytoskeleton and signaling proteins, orchestrating complex cellular processes essential for maintaining homeostasis and development.
仅用于科研。不用于诊断过程。未经明确授权不得转售。
篇参考文献 (0)
生物信息学
蛋白别名: Protein furry homolog
基因别名: 13CDNA73; 9330186A19Rik; AF346502; AI462658; C13orf14; C87180; cg003; D930046M03; FRY; Kiaa4143; mKIAA4143; RGD1307034
UniProt ID: (Mouse) E9Q8I9
Entrez Gene ID: (Mouse) 320365, (Rat) 304244




